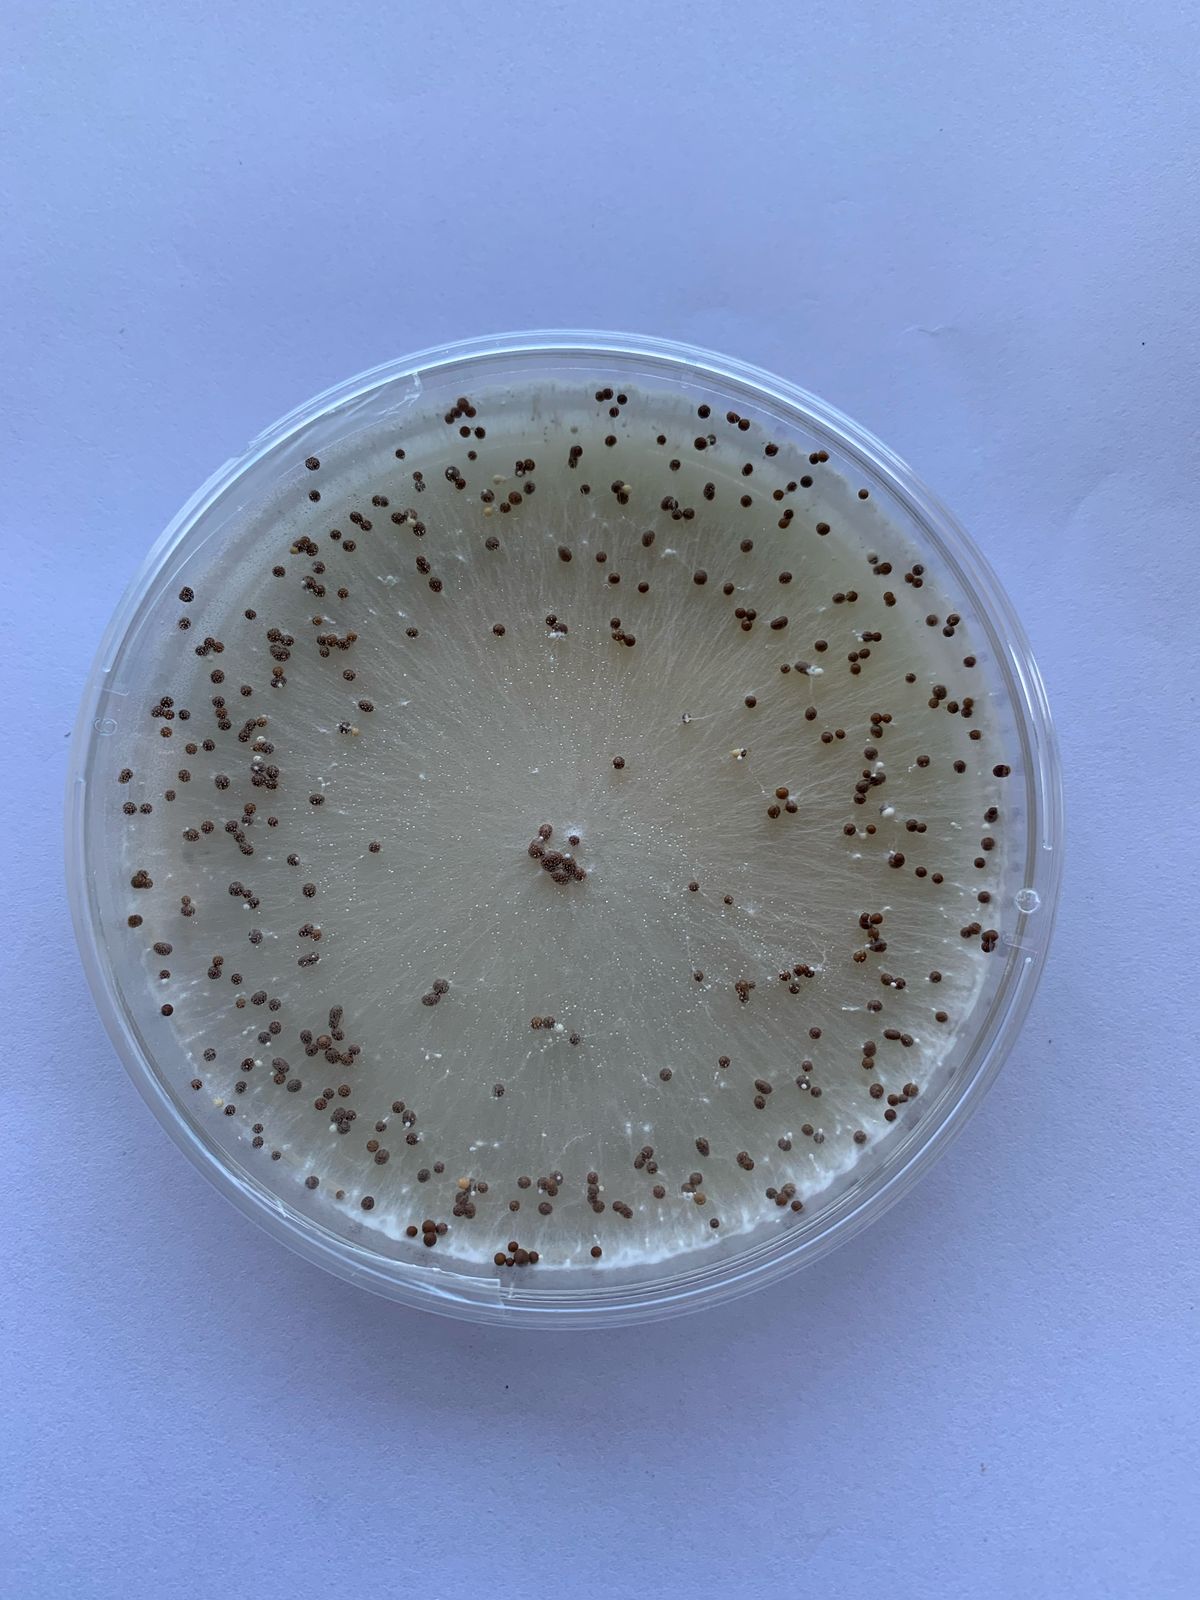

Sclerotium rolfsii (ook bekend as Agroathelia rolfsii en algemeen genoem suidelike verrotting, stamverrotting of wit skimmel) besmet meer as 500 plantspesies, insluitend gewilde gewasse soos grondbone, sonneblom, sojabone en aartappels. Grasse soos koring, gars, graansorghum en ander kan ook besmet word, hoewel dit minder algemeen is. Hierdie siekte kom wêreldwyd voor, veral in warm, vogtige klimate, en is moeilik om te beheer ondanks uitgebreide navorsing.
Siektesimptome
Op grondbone, droëbone, sonneblom en sojabone begin die siekte met ’n klein waterdeurdrenkte letsel aan die onderste stam (dikwels bekend as kraagverrotting), op of naby die grondoppervlak. Hierdie letsel versprei rondom die stam (Foto 1), wat lei tot verwelking van die plant. Die verwelkte blare verkleur gewoonlik eers geel en dan bruin, maar bly meestal aan die plant geheg.

Namate die onderste besmette dele van die stam begin verrot, ontwikkel daar ’n wit mat van swamdrade (miselia) rondom die letsel (Foto 2). Hierdie swammat versprei dikwels oor die omliggende grondoppervlak (Foto 3). Kort daarna, wanneer die swammat in ’n waaiervorm oor die grond versprei, vorm daar klein (0,5 tot 1 mm) wit ronde sklerotia. In droë toestande is die swamdrade minder sigbaar; in plaas daarvan kan wit tot ligbruin swamgroei teen die onderste stam voorkom, wat soos klein verfkolle lyk. Hierdie strukture word dan glad en rond en verkleur ligbruin, bruin of swart. Die sklerotia is oorwinteringstrukture en kom voor in die swamgroei, op siek weefsel net bo of onder die grondoppervlak. Die blaredak begin verwelk en afsterwing vind plaas as gevolg van stamverrotting. By sojabone en droëbone ontwikkel die onderste blare gewoonlik bruin kolle wat uitbrei. Die blare verkleur uiteindelik bruin en bly aan die stam geheg.


Biologie van die patogeen
Die patogeen het ’n ongeslagtelike stadium bekend as Sclerotium rolfsii, wat die tipiese simptome produseer soos hierbo beskryf. Die sklerotia wat vorm en ryp word, bestaan uit ’n dik, taai buitenste laag van swamdrade wat ’n laag dunwandige swamdrade omring. Sklerotia ontwikkel tot ’n deursnee van 0,5 tot 2 mm (Foto 4), maar sommige kan so groot as 10 mm wees. Segmente van swamdrade kan ook as inokulum dien en kan in plantreste of as sklerotia oorwinter. Daar is bewys dat sklerotia tot tussen drie en vier jaar in die grond kan oorleef. Die geslagtelike stadium van hierdie swam staan bekend as Agroathelia rolfsii, maar dit kom baie selde voor.
Siektesiklus en epidemiologie
Wanneer warm, nat toestande heers, ontkiem die sklerotia en besmet vatbare plante. Die swam is ’n nekrotrofiese grondpatogeen wat die beste naby die grondoppervlak oorleef. Beserings aan plante deur werktuie, aalwurms of insekte verhoog die risiko van infeksie. Die swam produseer oksaalsuur en ensieme wat plantselle doodmaak en infeksie vergemaklik. Die siekte kom algemeen in tropiese en subtropiese gebiede voor. Optimale groei en sklerotiavorming vind plaas tussen 27 en 35 °C, maar sklerotia kan selfs koue temperature oorleef. Die siekte versprei plaaslik deur kontak tussen plante en besmette grond, maar nie deur lugspore nie.
Invloed op gewasse
In gunstige toestande besmet sklerotia of swamdrade die stam naby die grondoppervlak, wat lei tot wit swamgroei, verwelking en plantafsterwing. Op grondbone kan een of twee takke afsterf, terwyl ander oorleef. In droë toestande ontstaan klein kankerletsels, maar in warm, nat toestande verrot die stam volledig. Peul- en peninfeksies is algemeen en lei tot peulverlies en swak kwaliteit. By sonneblomme neem die voorkoms van kraagverrotting toe in warm, vogtige toestande. Tipiese simptome sluit in vinnige verwelking en bruin letsels aan die stamvoet. Wit swamgroei en sklerotia vorm op die stam en omliggende grond.
Beheermaatreëls
Effektiewe beheer van S. rolfsii vereis ’n geïntegreerde benadering wat verskeie strategieë insluit. Kulturele praktyke speel ’n belangrike rol, en diep ploeg voor planttyd word aanbeveel om sklerotia dieper as 8 cm te begrawe, aangesien hulle swak oorleef in lae suurstoftoestande. Bewerkings tydens die seisoen moet vermy word om meganiese skade aan plante en die blootstelling van sklerotia te voorkom. Besproeiing moet versigtig beplan word om oormatige vog te vermy, met droë periodes tussen besproeiings wat die ontwikkeling van die siekte kan beperk. Wisselbou met niegasheergewasse soos mielies, sorghum of katoen vir minstens twee jaar help om inokulumvlakke te verminder, terwyl goeie onkruidbeheer nodig is om alternatiewe gashere te beperk. Waar moontlik, kan plantdatums gemanipuleer en aangepas word om hoë infeksietye te vermy, hoewel dit afhanklik is van betroubare weerdata en beskikbare reënval.
Chemiese beheer sluit die gebruik van geregistreerde swamdoders soos difenokonasool in. Dit kan effektief wees, veral wanneer dit gekombineer word met biologiese middels soos Trichoderma harzianum. Toedienings behoort ongeveer 70 dae na plant te begin, met twee tot vier toedienings teen intervalle van 14 dae, afhangend van siektedruk. Goeie penetrasie van die blaredak deur die swamdoder is belangrik sodat dit die stamvoet, waar infeksie plaasvind, effektief kan bereik.
Biologiese beheer is ’n relatief nuwe veld – Trichoderma harzianum het in studies die groei van S. rolfsii beperk. Verdere navorsing en toetsing van nuwe biologiese produkte word aanbeveel om alternatiewe en volhoubare beheeropsies te ontwikkel. Ten slotte is weerstandbiedende kultivars ’n belangrike komponent van siektebestuur. Alhoewel geen kultivar tans volledige weerstand teen S. rolfsii toon nie, bestaan daar sommige met gedeeltelike weerstand. In Suid-Afrika is plaaslike kultivars nog nie vir weerstand getoets nie, en toekomstige navorsing behoort daarop te fokus om geskikte weerstandbiedende materiaal te identifiseer vir gebruik in geïntegreerde siektebestuursprogramme.
Gevolgtrekking
S. rolfsii is ’n veelsydige en aanhoudende patogeen wat ernstige skade aan grondbone, droëbone, sonneblomme en sojabone kan veroorsaak, veral in warm en vogtige toestande. Die siekte se vermoë om vir jare in die grond te oorleef as sklerotia maak dit moeilik om te beheer, en geen kultivar bied tans volledige weerstand nie. Effektiewe bestuur vereis ’n geïntegreerde benadering wat diep ploeg, versigtige besproeiing, onkruidbeheer, gepaste wisselbou en doelgerigte gebruik van swamdoders insluit. Biologiese beheer en toekomstige navorsing oor weerstandbiedende kultivars kan verdere oplossings bied. Produsente moet dus proaktief wees in monitering en veldbestuur om die impak van hierdie siekte te beperk en opbrengsverliese te voorkom.
Vir verdere navrae kontak dr Belinda Janse van Rensburg by 018 299 6357.

















